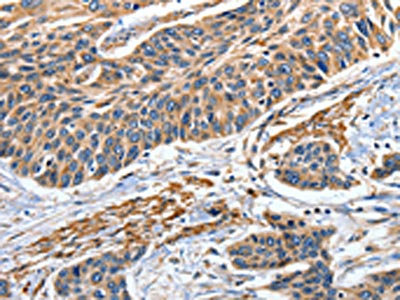

-
中文名稱:EFNB2兔多克隆抗體
-
貨號:CSB-PA035369
-
規格:¥1100
-
圖片:
-
The image on the left is immunohistochemistry of paraffin-embedded Human colon cancer tissue using CSB-PA035369(EFNB2 Antibody) at dilution 1/80, on the right is treated with fusion protein. (Original magnification: ×200)
-
The image on the left is immunohistochemistry of paraffin-embedded Human esophagus cancer tissue using CSB-PA035369(EFNB2 Antibody) at dilution 1/80, on the right is treated with fusion protein. (Original magnification: ×200)
-
-
其他:
產品詳情
-
Uniprot No.:
-
基因名:
-
別名:EFNB2; EPLG5; HTKL; LERK5; Ephrin-B2; EPH-related receptor tyrosine kinase ligand 5; LERK-5; HTK ligand; HTK-L
-
宿主:Rabbit
-
反應種屬:Human,Mouse
-
免疫原:Fusion protein of Human EFNB2
-
免疫原種屬:Homo sapiens (Human)
-
標記方式:Non-conjugated
-
抗體亞型:IgG
-
純化方式:Antigen affinity purification
-
濃度:It differs from different batches. Please contact us to confirm it.
-
保存緩沖液:-20°C, pH7.4 PBS, 0.05% NaN3, 40% Glycerol
-
產品提供形式:Liquid
-
應用范圍:ELISA,IHC
-
推薦稀釋比:
Application Recommended Dilution ELISA 1:2000-1:10000 IHC 1:100-1:300 -
Protocols:
-
儲存條件:Upon receipt, store at -20°C or -80°C. Avoid repeated freeze.
-
貨期:Basically, we can dispatch the products out in 1-3 working days after receiving your orders. Delivery time maybe differs from different purchasing way or location, please kindly consult your local distributors for specific delivery time.
-
用途:For Research Use Only. Not for use in diagnostic or therapeutic procedures.
相關產品
靶點詳情
-
功能:Cell surface transmembrane ligand for Eph receptors, a family of receptor tyrosine kinases which are crucial for migration, repulsion and adhesion during neuronal, vascular and epithelial development. Binds promiscuously Eph receptors residing on adjacent cells, leading to contact-dependent bidirectional signaling into neighboring cells. The signaling pathway downstream of the receptor is referred to as forward signaling while the signaling pathway downstream of the ephrin ligand is referred to as reverse signaling. Binds to receptor tyrosine kinase including EPHA4, EPHA3 and EPHB4. Together with EPHB4 plays a central role in heart morphogenesis and angiogenesis through regulation of cell adhesion and cell migration. EPHB4-mediated forward signaling controls cellular repulsion and segregation from EFNB2-expressing cells. May play a role in constraining the orientation of longitudinally projecting axons.; (Microbial infection) Acts as a receptor for Hendra virus and Nipah virus.
-
基因功能參考文獻:
- This is the novel report describing to demonstrate that the Runx2 expression of MSC is synergistically influenced by the hydrogels elasticity and their manner of ephrinB2 immobilized. PMID: 28300720
- the binding of the viral attachment protein G to its host receptor ephrinB2 was studied and showed monomeric and dimeric receptors activate distinct conformational changes in G. PMID: 28974687
- results suggest that ephrin-B2 overexpression and activation of the ephrin-B2 reverse signaling pathway in tumor microenvironment in OSCC facilitates progression and lymph node metastasis via enhancement of malignant potential and interaction with surrounding cells PMID: 29190834
- Proteomic analysis of their secretome reveals a signature, including ephrin-B2, that predicts decreased survival of glioma patients. We find that ephrin-B2 is an important pro-angiogenic tenascin-C effector. PMID: 27926865
- In human glioblastoma stem-like cells-derived orthotopic xenografts, EFNB2 knock-down blocked tumour initiation and treatment of established tumours with ephrin-B2-blocking antibodies suppressed progression. PMID: 27350048
- roles in stabilizing vascular-like structures generated by stem cells from apical papilla (SCAPs) and umbilical vein endothelial cells (HUVECs) PMID: 27451120
- High EFNB2 expression is associated with preeclampsia. PMID: 27069008
- Inhibition of EphB4 forward signaling using soluble EphB4 protein fused with murine serum albumin failed to affect eRMS model tumor progression, but did moderately slow progression in murine aRMS PMID: 28817624
- Study shows that EFNB2 is overexpressed in head and neck squamous cell carcinoma, pancreatic adenocarcinoma, and urothelial bladder carcinoma, and its overexpression correlates with poor survival of the cancer patients. PMID: 27649287
- Five SNPs in the 3' region of the EFNB2 were in linkage disequilibrium and significantly associated with hypertension for male but not female subjects. PMID: 27530629
- These results indicate a novel mechanism of ephrin-Eph signaling independent of direct cell contact and proteolytic cleavage and suggest the participation of EphB2(+)extracellular vesicles in neural development and synapse physiology. PMID: 27354374
- Association of EFNB2 rs9520087 with symptoms of schizophrenia in Chinese Zhuang and Han populations. PMID: 27028544
- miR-137 directly down-regulates the expression of EFNB2, and a genetic variant in the RNA binding site in EFNB2 gene affects the expression regulation. MiR-137, as a risk factor for schizophrenia PMID: 27650867
- 5-fluorouracil-induced ephrin-B2 reverse signaling promotes tumorigenesis through the Src-ERK pathway, and drives EMT via the Src-FAK pathway. PMID: 26494468
- Together, these findings suggest that CCL2, RARRES2 and EFNB2 are host cell factors involved in respiratory syncytial virus replication. PMID: 26277777
- These genes may be potential biomarkers for identification of subclinical lymph node involvement in papillary thyroid carcinoma (PTC) PMID: 24634162
- increased notably in preeclampsia endothelial progenitor cells and placenta PMID: 26212082
- Results suggest a potential signalling hierarchy between Delta-like 1 and ephrin-B2 ligands, as neural stem cells adopt the Delta-like 1 phenotype of stem cell maintenance on simultaneous presentation of both signals. PMID: 26754526
- role in maternal spiral artery remodeling in first trimester PMID: 25748802
- EfnB2 is an essential regulator of endothelial cell death and vessel pruning. This regulation depends upon phosphotyrosine-EfnB2 signaling repressing JNK3 activity via STAT1. PMID: 25807892
- Results suggest that ephrinB2 may function as a colorectal cancer cells growth stimulator. PMID: 25434750
- Molecular recognition of human ephrinB2 cell surface receptor by an emergent African henipavirus. PMID: 25825759
- Data suggest that fusion of Nipah viruses with host cells is facilitated by two of viral membrane proteins, the G protein and the F protein; G head domain binds to human ephrins B2 and B3 altering conformational density of entire G head domain. PMID: 24615845
- Human ephrin-B2 is poorly cleaved by KLK4 while the homologous mouse is not. PMID: 25724897
- Downregulation of the endothelial genes Notch1 and ephrinB2 in patients with nodular regenerative hyperplasia. PMID: 23870033
- EphB4 and ephrin B2 play important roles in neovascularization and arteriovenous differentiation/plasticity. PMID: 24517927
- Despite the negative results of our mutation screening, we still consider EFNB2 an excellent candidate gene for contributing to the development of Anorectal malformations in humans. PMID: 24038947
- EphB2 and Ephrin-B2 interactions mediate human mesenchymal stem cell suppression of activated T-cells. PMID: 23711177
- NNMT expression regulates neurone morphology in vitro via the sequential activation of the EFNB2 and Akt cellular signalling pathways. PMID: 23764850
- High levels of ephrinB2 over-expression increases the osteogenic differentiation of human mesenchymal stem cells PMID: 23201622
- EphrinB2 is an important indicator of poorly differentiated hepatocarcinoma. PMID: 22024229
- Specific Ab-based ephrinB2 targeting may represent an effective therapeutic strategy to be used as an alternative or in combination with existing antiangiogenic drugs for treating patients with cancer and other angiogenesis-related diseases. PMID: 22446484
- Monoclonal antibody developed in this study may be used as a reagent to probe ephrin-B2 distribution in normal as well as in pathological conditions and to antagonize ephrin-B2 interaction with EphB4 for basic science and therapeutic applications. PMID: 22292016
- The expressions of ephrinB2 and EphB4 were significantly higher in NSCLC tissue than in control tissues, and were positively correlated with lymphatic metastasis. PMID: 21575518
- deregulated ephrin-B2 expression interferes with the regulation of the stem cell niche and leads to a shift of the differentiation pathway and may thereby contribute to the acquisition of the metastatic phenotype PMID: 22020958
- ephrin-B2-EphB4 signaling between PDLF and osteoblasts of the alveolar bone might contribute to osteogenesis at tension sites during orthodontic tooth movement PMID: 21880727
- Results indicated that the G-H loop of ephrin-B2 was indeed critical for the interaction between ephrin-B2 and Nipah virus-G. PMID: 21632558
- EphB4/ephrinB2 interactions between tumor cells and endothelial cells identify a mechanism for site-specific metastatic dissemination of tumor cells. PMID: 21047731
- High ephrin-B2 is associated with malignant urogenital tissue. PMID: 19272799
- The find of this study indicated that EFNB2 gene may be a candidate susceptibility gene for schizophrenia in the Han Chinese population. PMID: 20483485
- The data indicate that MSCs expressing Ephrin-B2 represent a novel proangiogenic cell source to promote neovascularization in ischemic tissues. PMID: 20491587
- Ephrin-B2 is a potent regulator of endothelial cell behavior, and indicate that the control of cell migration and angiogenesis by ephrins might involve both receptor-dependent and receptor-independent activities. PMID: 20233847
- The crystal structure of the EphA4 ligand-binding domain in complex with ephrin-B2, is reported. PMID: 19875447
- ephrin-B2 plays a critical role in glioma invasion PMID: 19728339
- expressed differentially in colon carcinoma and normal mucosa specimens and may play a role in progression of colon carcinoma PMID: 11920461
- Endogenous ephrin B2 from human umbilical artery endothelial cells activates a kinase that phosphorylates murine GST-ephrin-B1 cytoplasmic domain fusion proteins. PMID: 11983165
- role of ephrin-B2 in erythropoiesis PMID: 12051776
- The entire cytoplasmic domain of ephrin-B2 and its N-terminal fragment, residues 253-300, lack the ability to fold into a well-defined three dimensional structure and are particularly prone to aggregation. PMID: 12206665
- These data identify distinct propulsive and repulsive effector functions of endothelial ephrinB2 and EphB4 that mediate spatial positional signals during angiogenesis and vessel assembly. PMID: 12734395
- ephrin B2 is present in human retinal endothelial cells and vascular growth may be modulated in the retina through activation of the PI3K pathway. PMID: 14499344
顯示更多
收起更多
-
亞細胞定位:Cell membrane; Single-pass type I membrane protein. Cell junction, adherens junction.
-
蛋白家族:Ephrin family
-
組織特異性:Lung and kidney.
-
數據庫鏈接:
Most popular with customers
-
-
YWHAB Recombinant Monoclonal Antibody
Applications: ELISA, WB, IHC, IF, FC
Species Reactivity: Human, Mouse, Rat
-
-
-
-
-
-
VDAC1 Recombinant Monoclonal Antibody
Applications: ELISA, WB, IHC
Species Reactivity: Human, Mouse, Rat